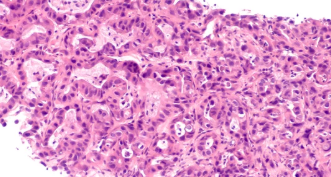

췌장암 증상 – 조용히 진행되지만 치명적인 암, 이런 신호가 보이면 반드시 의심하세요
- 카테고리 없음
- 2025. 5. 22. 20:10
췌장암 증상 – 조용히 진행되지만 치명적인 암, 이런 신호가 보이면 반드시 의심하세요
췌장암은 **초기 증상이 거의 없고 발견 시 이미 진행된 경우가 많아 ‘침묵의 암’**이라 불립니다.
진단 시 환자의 절반 이상이 3기 이상으로 발견되며, 5년 생존율은 10%도 채 되지 않을 만큼 치명적인 암 중 하나입니다. 하지만 조기 발견만 가능하다면 치료 성공률은 훨씬 올라갑니다.
따라서 작은 이상 신호라도 무심코 넘기지 않는 것, 그것이 생명을 지키는 시작입니다.
이 글에서는 췌장암의 초기 증상부터 진행성 증상, 오진되기 쉬운 증상들까지 꼼꼼히 안내해드릴게요.
1. 췌장암이란?

췌장은 위 뒤쪽에 위치한 기관으로, 소화 효소 분비와 인슐린·글루카곤 등 혈당 조절 호르몬을 생산하는 장기입니다.
췌장암은 이 췌장 조직에 비정상적인 암세포가 생겨 빠르게 퍼지는 악성 종양으로, 특히 **췌장 머리 부분(두부)**에 가장 자주 발생합니다.
2. 췌장암 초기증상 – 흔하지만 놓치기 쉬운 변화들



췌장암 초기에는 증상이 모호하고 일반적인 소화불량과 유사해 쉽게 넘길 수 있습니다. 그러나 다음과 같은 증상이 지속적으로 반복된다면 정밀 검사가 필요합니다.
✅ 1) 복부 통증 및 등 통증
- 명치 또는 상복부 통증이 등 쪽으로 퍼지는 느낌
- 누우면 통증이 심해지고, 앉거나 몸을 앞으로 굽히면 조금 완화됨
✅ 2) 소화불량, 식욕부진
- 기름진 음식 섭취 후 소화가 잘 안 되거나 속이 더부룩
- 갑자기 입맛이 떨어지고 소식하게 되는 경우
✅ 3) 체중 감소
- 특별한 다이어트나 운동 없이 한 달 새 3kg 이상 급격한 체중 감소
- 식욕은 평소와 비슷해도 살이 빠지는 경우 의심
✅ 4) 잦은 설사 또는 지방변
- 기름기 있는 변이 물에 뜨고 잘 내려가지 않음 (지방 흡수 장애)
- 하루 2회 이상 묽고 냄새 강한 설사가 반복될 경우 의심
✅ 5) 황달
- 피부와 눈 흰자가 노랗게 변함
- 췌장암이 담도계를 막아 빌리루빈이 배출되지 못하면서 발생
- 소변색이 콜라색처럼 진해지고, 대변은 회색·흰색으로 나올 수 있음
✅ 6) 잦은 구토, 오심
- 특히 음식 섭취 직후 구역질, 메스꺼움 반복
- 위와 십이지장을 누르면서 출구폐색 증상처럼 나타날 수 있음
3. 췌장암 진행 시 나타나는 증상



증상 설명
| 복부 팽만 및 복수 | 암세포 복막 전이로 복수가 차면서 배가 불러짐 |
| 심한 피로감 및 무기력 | 혈당 이상, 암 독소에 의한 전신 쇠약 |
| 등 통증 심화 및 야간 통증 | 암이 복강신경총 침범 시 지속적 통증 |
| 당뇨병 악화 또는 급성 발생 | 인슐린 분비장기 손상으로 갑자기 혈당 불안정 |
| 심부정맥 혈전증(DVT) | 정맥에 혈전이 자주 생김 (췌장암의 경고 증상 중 하나) |
4. 오진되기 쉬운 증상 vs 췌장암의 실제 증상



일반 질환 증상처럼 보이지만… 췌장암 의심 필요 상황
| 소화불량, 위염 증상 | 위약 없이도 수주간 계속되는 상복부 불쾌감 |
| 체중 감소 | 식욕은 있는데 살이 빠진다면 내장 질환 의심 |
| 설사 또는 과민성 장 증상 | 기름진 변이 자주 뜨거나 잘 내려가지 않음 |
| 당뇨병 증상 | 기존 당뇨가 갑자기 악화되거나 혈당이 급격히 변함 |
5. 고위험군이라면 이런 증상에 더 주의하세요



고위험군 분류 설명
| 만성 췌장염 환자 | 장기 염증이 암으로 이어질 가능성 ↑ |
| 가족 중 췌장암 병력 | 직계 가족력이 있으면 발병 위험 2~3배 ↑ |
| 흡연자 | 담배는 췌장암의 강력한 원인 중 하나 |
| 고지방 식단, 비만자 | 췌장 기능 저하 및 지방간 동반 위험 ↑ |
| 50세 이상 + 당뇨병 | 중장년 이후 당뇨 발병자는 췌장 이상 동반 가능성 ↑ |
6. 췌장암 진단 방법
검사명 목적
| 복부 CT | 췌장 및 주변 장기 상태 확인, 암 병기 판단 가능 |
| MRI / MRCP | 담도·췌관 구조 확인, 담도 폐색 여부 진단 |
| 내시경 초음파(EUS) | 미세 병변 확인 및 조직 검사 병행 가능 |
| 종양표지자 검사(CA 19-9) | 수치 상승 시 암 가능성 의심 (단, 확진은 아님) |
7. 이런 변화가 있다면 꼭 병원에 가세요
- 2주 이상 지속되는 상복부 통증 + 등 통증
- 명확한 이유 없이 급격한 체중 감소
- 기름진 변, 설사가 자주 반복됨
- 황달, 짙은 소변, 회색 변이 보임
- 당뇨가 악화되었거나, 처음으로 진단받았는데 동반된 복부 통증이 있음